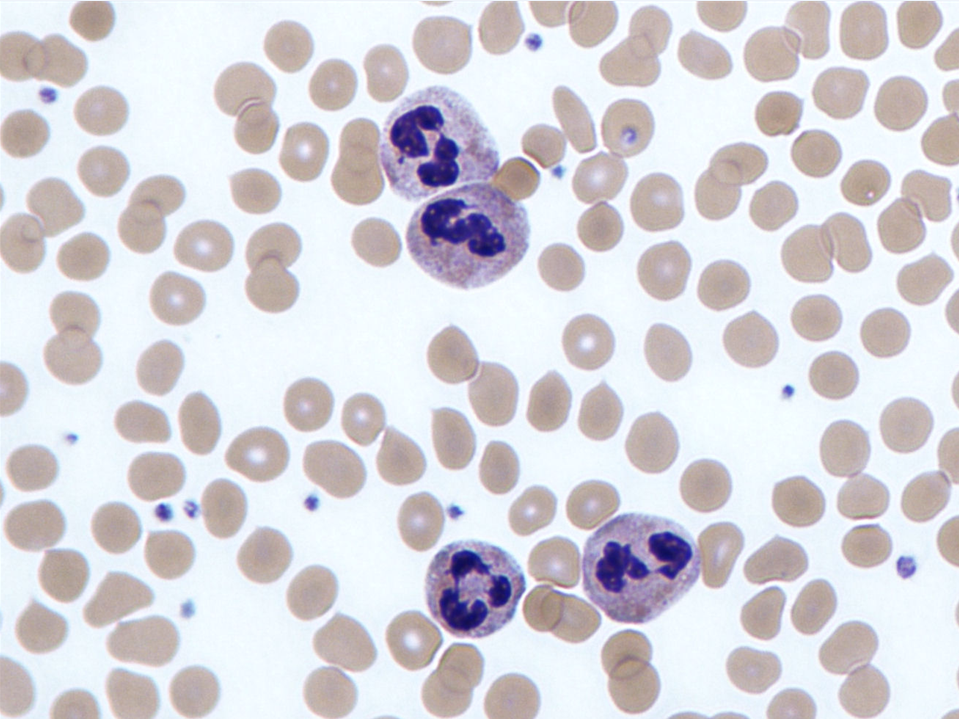
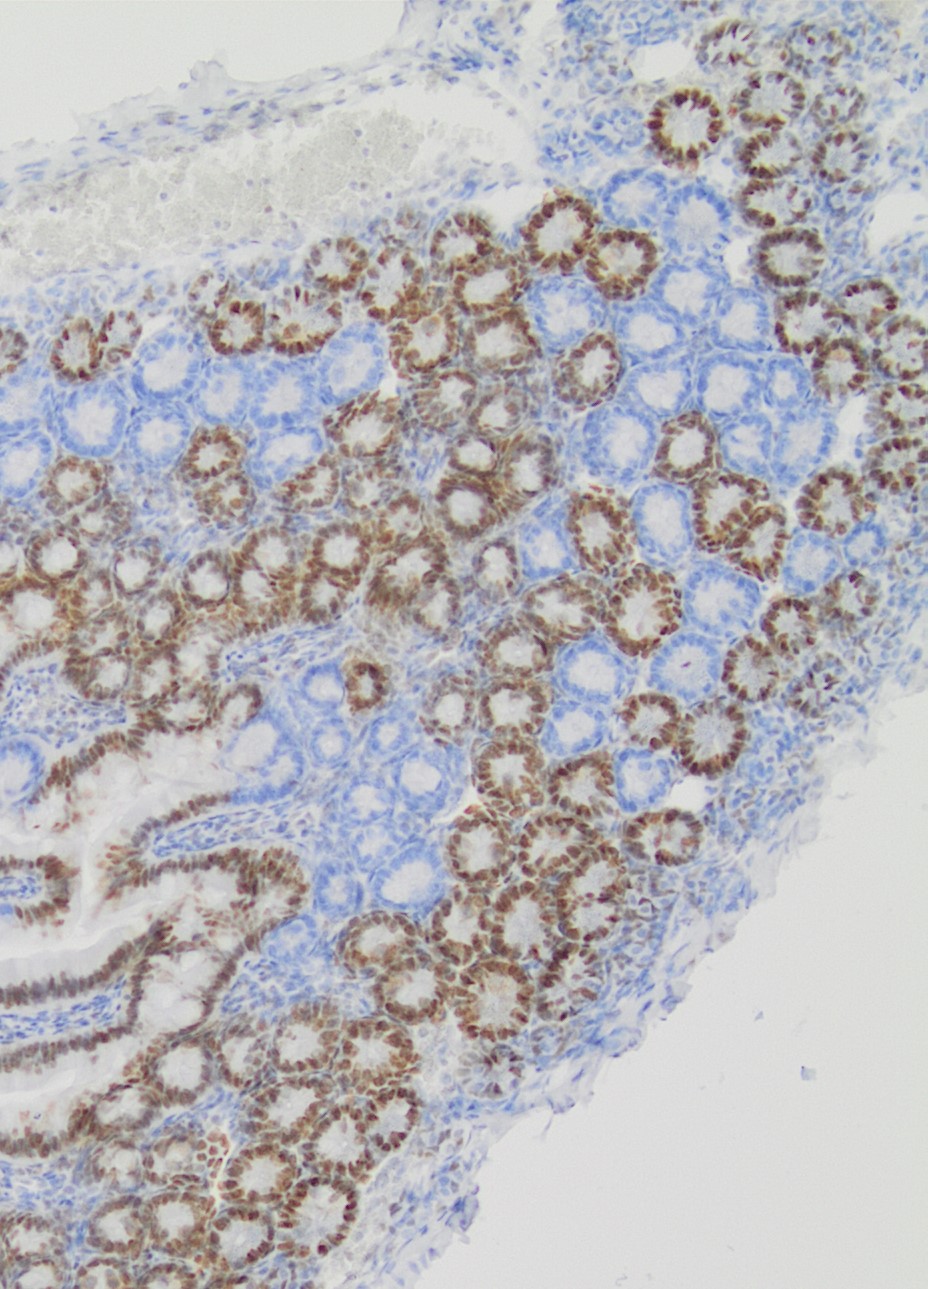

Fundamental Research
The search for the vulnerabilities of cancer cells
In order to find the vulnerabilities of cancer cells and treat cancer, we need to understand the biology of cancer. How do cancer cells differ from healthy cells, and how do they interact with their environment, or with therapies?
The Netherlands Cancer Institute has designated fundamental research as one of its five overarching research themes. Together, our researchers form a highly international, vibrant, and curiosity-driven community, working in close collaboration with the clinicians from our hospital towards one shared goal: tackling the huge societal challenge we call cancer.